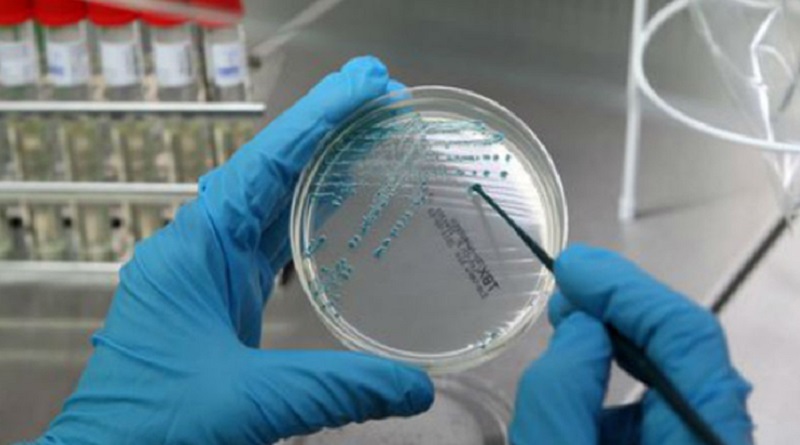

Inquinamento fiume Chiese e legionella 2018, riunione in Prefettura per studiare la situazione
Nella tarda mattinata di ieri, il Prefetto di Brescia, dr. Annunziato Vardè, ha presieduto un incontro interistituzionale per favorire un confronto diretto sui principali profili sanitari ed ambientali connessi alle molteplici problematiche inerenti l’inquinamento del fiume Chiese che, si ritiene, possa aver inciso sulla anomala diffusione della “legionella” verificatasi nella decorsa estate.
All’incontro hanno preso parte, i rappresentanti del “Tavolo delle associazioni che amano il fiume Chiese” e del Comitato di salute pubblica, costituitosi all’indomani della predetta epidemia di legionella – e già ascoltati dal Prefetto in un precedente incontro dedicato al medesimo tema -, il direttore dell’U.T.R., il Capo di Gabinetto della Provincia di Brescia, il Direttore Generale ed il Direttore Sanitario dell’ATS di Brescia, i sindaci – o i delegati – dei comuni di Acquafredda, Calcinato, Calvisano, Carpenedolo, Isorella, Lonato e Montichiari, individuati tra quelli maggiormente interessati dal fenomeno epidemiologico in questione, nonché un delegato dell’ARPA.
L’incontro si è aperto con un’ampia illustrazione, da parte del Direttore Generale dell’ATS bresciana, degli esiti dell’indagine epidemiologica condotta dallo stesso Ente fin dalla fase acuta del fenomeno, e conclusa proprio in questi giorni.
L’indagine ha posto in evidenza che il numero dei casi di legionella registrati, tra la fine di agosto e la prima metà di settembre 2018, testimonia un fenomeno epidemico eccezionale, probabilmente determinato da una combinazione di fattori, comunque transitori.
Tra le cause più significative è stata segnalata la formazione, per via della siccità, di pozze stagnanti d’acqua nel fiume Chiese che, come noto, costituiscono un habitat favorevole alla proliferazione dei batteri. Altre concause sarebbero rappresentate dalle alte temperature e dalle improvvise, abbondanti precipitazioni (c.d. “bombe d’acqua”) che, grazie alla nebulizzazione dell’acqua, avrebbero favorito la diffusione in aria del batterio della legionella.
I sindaci intervenuti, dopo aver mostrato apprezzamento per l’iniziativa assunta da questa Prefettura, si sono resi interpreti del persistente preoccupazione delle comunità amministrate, rappresentando l’esigenza di essere edotti (in maniera ufficiale) della situazione e delle misure di prevenzione programmate dagli organi competenti.
Altra preoccupazione espressa al tavolo odierno è quella relativa allo “stato di salute” del fiume Chiese atteso che lo stesso, oltre ad essere caratterizzato da scarsi flussi idrici, è ricettore di diversi scarichi (anche di tipo industriale). In tale contesto è stato evidenziato che, in assenza di alcun intervento da parte delle istituzioni, mirato ad invertire la tendenza, è possibile che il fenomeno registrato lo scorso anno si ripeta.
Al termine del tavolo è stato, quindi, concordato che l’ATS di Brescia promuova, a breve, un incontro pubblico con i sindaci rivieraschi per informarli delle risultanze dell’indagine epidemiologica in questione e sulle misure sanitarie e ambientali da porre in essere – anche a cura dei sindaci, per quanto di loro competenza – per prevenire altri, futuri contagi.
Per garantire, poi, maggiori rilasci idrici nel fiume e gli altri interventi di salvaguardia ambientale delle acque stesse è stato proposto che l’Ufficio territoriale della Regione Lombardia, istituisca un tavolo tecnico con tutte le istituzioni e le associazioni di categoria interessate per definire una soglia delle acque del Chiese che, senza sacrificare gli interessi economici delle categorie produttive, ne garantisca la salubrità.
La Prefettura continuerà a monitorare l’esito di tutte le iniziative promosse dalle citate istituzioni supportandone l’azione.